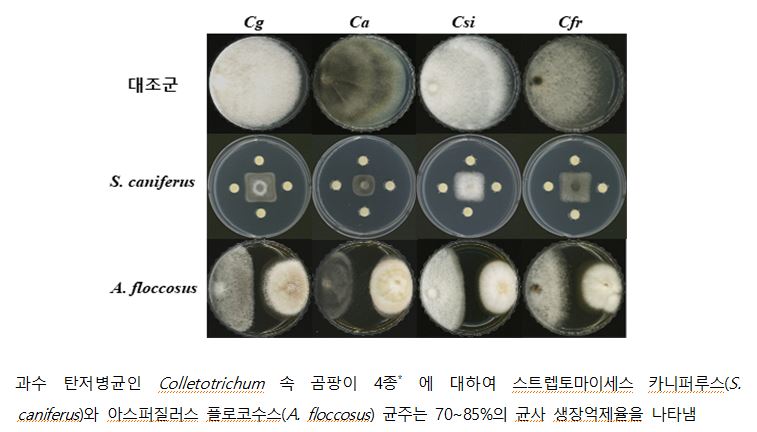
▲ ⓒ

국립낙동강생물자원관 연구진… 새로운 작물보호제 소재로 활용 기대
-
- ▲ ⓒ
경북 상주시에 있는 국립낙동강생물자원관은 최근 안양천 등에서 ‘과일 곰팡이병(과수 탄저병)’ 억제 효능을 지닌 신규 항균물질을 발견했다고 20일 밝혔다.자원관 연구진은 2021년부터 ‘담수균류 유래 바이오 작물보호제용 원천소재 발굴’ 연구과제를 수행하며 유용 담수균류를 확보하고 이를 활용한 작물보호제 개발 연구를 하고 있다.이 과정에서 과수 탄저병균(Colletotrichum sp.)에 대해 항균 효과를 나타내는 균주 2종(아스퍼질러스 플로코수스(Aspergillus floccosus), 스트렙토마이세스 카니퍼루스(Streptomyces caniferus)을 발견했다.두 균주는 과수 탄저병균의 균사생장을 70% 이상 억제하는 것으로 나타났다.이와 함께 동일한 균주를 고추 모종에 처리했을 때 줄기 길이와 굵기가 30% 증가하는 점이 확인돼 식물생장 촉진능력도 입증됐다.해당 연구 결과는 10월 안으로 특허가 출원될 예정이다.또 2019년 3월에 같은 안양천에서 발견한 에드니아(Edenia sp.) 균주에서도 과수 탄저병 병원균에 대한 항균효과를 확인했다.연구진은 후속 연구를 통해 에드니아 균주가 생산하는 새로운 구조의 펩타이드계 항균물질 2가지를 발견했고 현재 이를 활용한 과수 탄저병 방제용 친환경 작물보호제 실증 연구를 하고 있다.김의진 생물자원연구실장은 “국내 담수환경에서 발견한 생물자원으로부터 과수 탄저병 방제에 활용 가능한 새로운 소재를 확보한 데 큰 의미가 있다”며, “앞으로도 담수생물자원의 실용화를 위한 연구를 추진하겠다"고 밝혔다.







